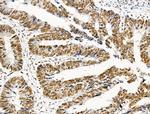
Phospho-NPM1 (Ser125) Antibody in Immunohistochemistry (Paraffin) (IHC (P))

Search
Invitrogen
Phospho-NPM1 (Ser125) Polyclonal Antibody
{{$productOrderCtrl.translations['antibody.pdp.commerceCard.promotion.promotions']}}
{{$productOrderCtrl.translations['antibody.pdp.commerceCard.promotion.viewpromo']}}
{{$productOrderCtrl.translations['antibody.pdp.commerceCard.promotion.promocode']}}: {{promo.promoCode}} {{promo.promoTitle}} {{promo.promoDescription}}. {{$productOrderCtrl.translations['antibody.pdp.commerceCard.promotion.learnmore']}}
图: 1 / 15
Phospho-NPM1 (Ser125) Antibody (PA5-114612) in ICC/IF

Please note: We are reviewing Western blot images included in the antibody testing data in our catalog, including those provided by third parties. Unless expressly labeled or annotated as “raw-unedited”, Western blot images included in the antibody testing data in our catalog may have been edited, optimized or otherwise adjusted for presentation.
产品信息
PA5-114612
种属反应
宿主/亚型
分类
类型
抗原
偶联物
形式
浓度
规格
纯化类型
保存液
内含物
保存条件
运输条件
RRID
产品详细信息
Antibody detects endogenous levels of Nucleophosmin only when phosphorylated at Ser125.
靶标信息
NPM1 (Nucleophosmin 1, B23, nutramin, NO38) is a ubiquitously expressed phosphoprotein involved in ribosome assembly/transport, cytoplasmic/nuclear trafficking, regulation of DNA polymerase alpha activity, centrosome duplication, and regulation of p53. NPM1 continuously shuttles between the nucleus, cytoplasm, nucleolus and chaperoning core histones from the nucleus to the cytoplasm. NPM1 has been shown to bind nucleic acid, prevent protein aggregation via its chaperon activities, protect enzymes during thermal denaturation, and facilitate renaturation of chemically denatured proteins. In its cellular structure role, there is evidence suggesting NPM1 is associated with the centrosome, and is the substrate of CDK2/cyclin E during duplication of centrosomes (cellular division). Due to the NPM1 gene interaction with several tumor-associated chromosome translocations, NPM1 is thought to be a portion of several fusion proteins: NPM-ALK, NPM-RAR, and NPM-MLF1. While it is not thought to be part of the transforming potential of these fusion proteins, NPM1 is believed to act as the interface for oligomerization and oncogenic conversion of these tumor promoting fusion proteins. Further, NPM1 is also known to sequester the tumor suppressor RF in the nucleolus, protecting it from degradation until it is necessary. Dysfunction of the NPM1 protein is associated with diseases such as acute myeloid leukemia and lymphomatoid papulosis.
仅用于科研。不用于诊断过程。未经明确授权不得转售。
篇参考文献 (0)
生物信息学
蛋白别名: B23 antibody; MGC104254; mNPM antibody; mNPM1 antibody; NO38 antibody; NPM; Nucleolar phosphoprotein B23; nucleolar protein B23.1; Nucleolar protein NO38; Nucleophosmin; nucleophosmin 1; Numatrin; numatrin antibody
基因别名: B23; B23NP; NO38; NPM; NPM1
UniProt ID: (Rat) P13084, (Mouse) Q61937
Entrez Gene ID: (Rat) 25498, (Mouse) 18148




